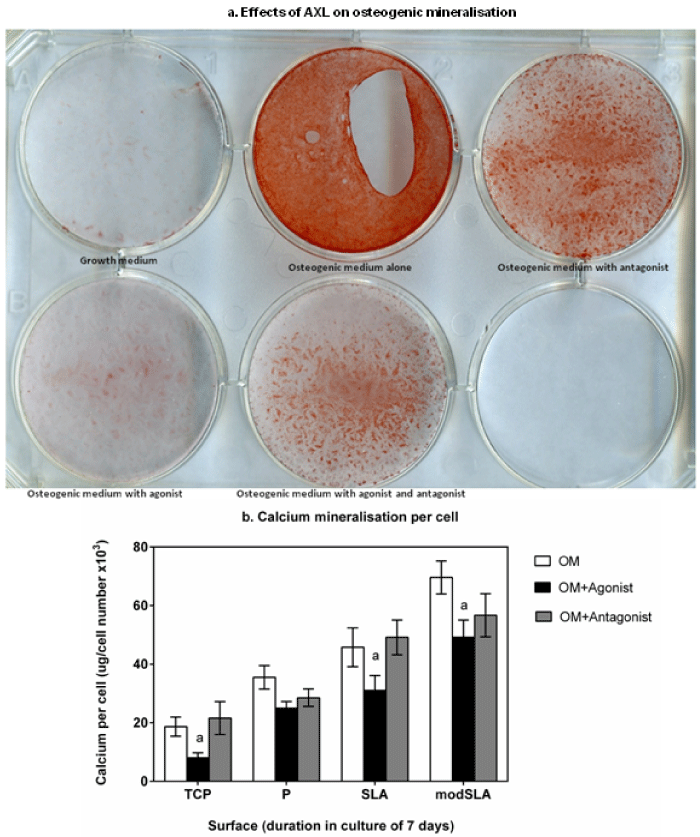

|
| Figure 3: Effects of AXL signaling disruption on extracellular matrix calcium mineralisation were assayed. (a) hMSC cultured in different conditions for 14 days and stained with a 2% Alizarin Red S were imaged on a flatbed scanner. GM showed no stain. OM stained intensely. Antagonist stained positive though intensity was lesser than OM alone. The agonist had caused a strong decline in staining intensity compared to control and OM with antagonist. The combination of both media supplements led to an intermediate stain. (b) Cells were cultured on all surfaces with OM, OM with agonist or OM with antagonist for 7 d; calcium quantities and cell numbers assayed. Control OM induced mineralisation in an order of modSLA > SLA > P > TCP. The additions of agonist significantly decreased mineralisation on each surface respective to controls; but did not inhibit the process. This effect was most prominent on the TCP. The addition of antagonist did not increase calcium mineralisation on all surfaces; P and modSLA cultured cells displayed a small decrease in presence of antagonist. Error bars show mean ± 1SD; N=3, n=3. a= p<0.05, control vs. condition for any surface. |